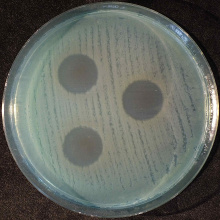
Bakterie na szalce Petriego

An innovative agent combating antibiotic-resistant bacteria, Pseudomonas aeruginosa (blue pus bacillus), based on the synergy of naphthoquinone and silver nanoparticles, has been granted patent protection by the Polish Patent Office. The invention was developed by scientists from the Intercollegiate Faculty of Biotechnology UG and MUG, the Faculty of Chemistry UG and the Faculty of Chemistry GdańskTech.
Infections caused by Pseudomonas aeruginosa (green pus bacillus) pose a serious challenge to modern medicine due to the high degree of resistance of this bacterium to antibiotics and its significant virulence. Pseudomonas aeruginosa is an opportunistic pathogen, which means that it is present in the environment and in humans without causing disease, but becomes dangerous when the immune system is weakened, e.g. in patients with chronic diseases, the elderly or patients with chronic wounds.
An interdisciplinary team of researchers from the University of Gdańsk and Gdańsk University of Technology has developed an effective preparation based on silver nanoparticles and naphthoquinone that combats Pseudomonas aeruginosa by inhibiting the growth and actively killing the cells of this pathogen.

Dr Marta Krychowiak-Maśnicka at the lab
This is the seventh patent for innovative antibacterial agents that combat Pseudomonas aeruginosa infections, which the Polish Patent Office has granted to dr Marta Krychowiak-Maśnicka and her co-researchers.
The newly granted patent is the result of the cooperation of an interdisciplinary team of scientists, including: dr Marta Krychowiak-Maśnicka (Principal Investigator) and prof. dr hab. Aleksandra Królicka from the Department of Biologically Active Compounds Research of the Intercollegiate Faculty of Biotechnology UG and MUG, dr Aleksandra Bielicka-Giełdoń from the Faculty of Chemistry at the University of Gdańsk and dr Ewa Paluszkiewicz from the Faculty of Chemistry at Gdańsk University of Technology.
‘Our preparation utilises the synergy between silver and naphthoquinones, i.e. the mutual enhancement of the antibacterial activity of these two agents. Thanks to this synergy, very low doses of silver and naphthoquinones, which do not exhibit antibacterial activity when used separately, have a strong bactericidal effect when combined, effectively combating bacteria,’ explains dr Marta Krychowiak-Maśnicka. ‘The use of synergistic combinations is crucial for limiting the development of resistance by bacteria, and thus prolonging the usefulness of a given substance in the treatment of bacterial infections. The preparation uses silver nanoparticles, which are an innovative and less toxic alternative to silver salts.’
Work on the use of synergy to increase the effectiveness of silver in combating bacterial pathogens is being continued by dr Marta Krychowiak-Maśnicka, and the results will be published soon.
‘Currently, the research is focused on deepening our understanding of the mechanism of synergy and on finding a business partner interested in the practical application of our research results,’ adds the scientist.
The process of securing intellectual property rights for the invention was carried out with the support of a team of specialists from the UG Technology Transfer Office, led by Director Katarzyna Gronowska.